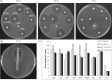

Repeated isolation of an antibiotic-dependent and temperature-sensitive mutant of Pseudomonas aeruginosa from a cystic fibrosis patient
- PMID: 33259594
- PMCID: PMC7879151
- DOI: 10.1093/jac/dkaa482
Repeated isolation of an antibiotic-dependent and temperature-sensitive mutant of Pseudomonas aeruginosa from a cystic fibrosis patient
Abstract
Background: Bacteria adapt to survive and grow in different environments. Genetic mutations that promote bacterial survival under harsh conditions can also restrict growth. The causes and consequences of these adaptations have important implications for diagnosis, pathogenesis, and therapy.
Objectives: We describe the isolation and characterization of an antibiotic-dependent, temperature-sensitive Pseudomonas aeruginosa mutant chronically infecting the respiratory tract of a cystic fibrosis (CF) patient, underscoring the clinical challenges bacterial adaptations can present.
Methods: Respiratory samples collected from a CF patient during routine care were cultured for standard pathogens. P. aeruginosa isolates recovered from samples were analysed for in vitro growth characteristics, antibiotic susceptibility, clonality, and membrane phospholipid and lipid A composition. Genetic mutations were identified by whole genome sequencing.
Results: P. aeruginosa isolates collected over 5 years from respiratory samples of a CF patient frequently harboured a mutation in phosphatidylserine decarboxylase (psd), encoding an enzyme responsible for phospholipid synthesis. This mutant could only grow at 37°C when in the presence of supplemented magnesium, glycerol, or, surprisingly, the antibiotic sulfamethoxazole, which the source patient had repeatedly received. Of concern, this mutant was not detectable on standard selective medium at 37°C. This growth defect correlated with alterations in membrane phospholipid and lipid A content.
Conclusions: A P. aeruginosa mutant chronically infecting a CF patient exhibited dependence on sulphonamides and would likely evade detection using standard clinical laboratory methods. The diagnostic and therapeutic challenges presented by this mutant highlight the complex interplay between bacterial adaptation, antibiotics, and laboratory practices, during chronic bacterial infections.
© The Author(s) 2020. Published by Oxford University Press on behalf of the British Society for Antimicrobial Chemotherapy. All rights reserved. For permissions, please email: journals.permissions@oup.com.
Figures

References
-
- Stover CK, Pham XQ, Erwin AL. et al. Complete genome sequence of Pseudomonas aeruginosa PA01, an opportunistic pathogen. Nature 2000; 406: 959–64. - PubMed
Publication types
MeSH terms
Substances
Grants and funding
LinkOut - more resources
Full Text Sources
Medical
Molecular Biology Databases